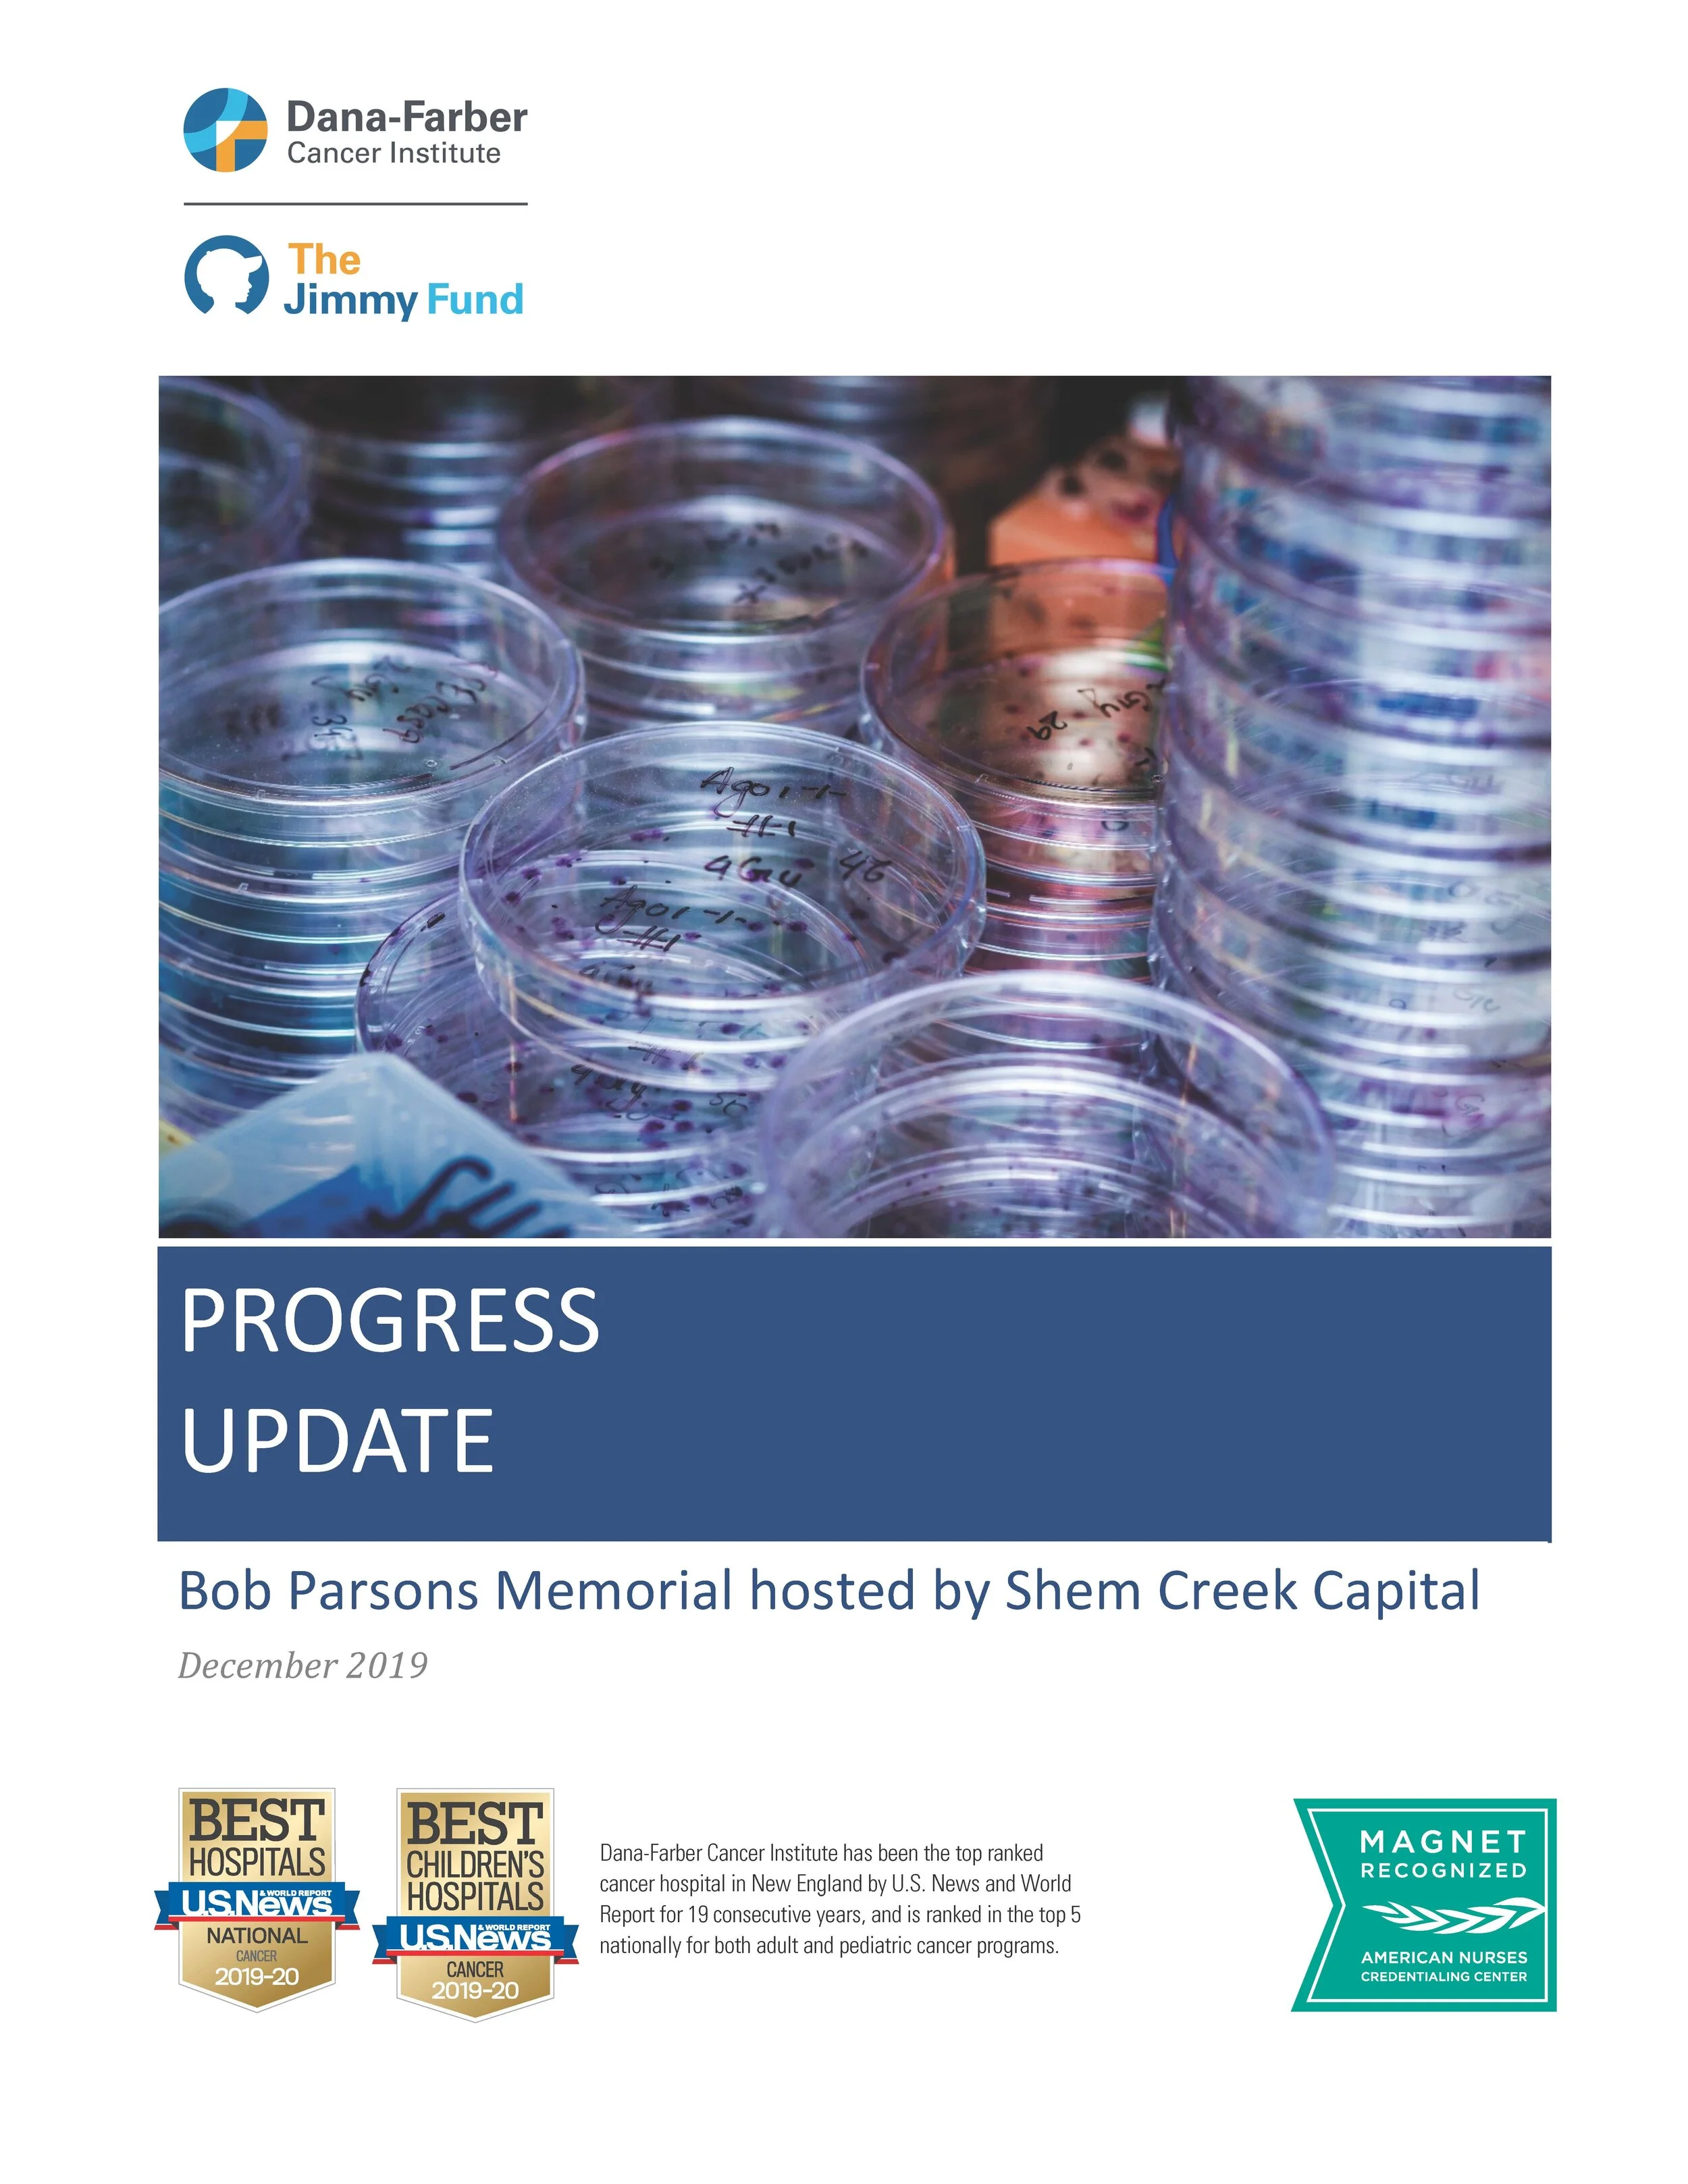

Thank you to our sponsors, donors, friends and family who have continued to drive the success of the Bob Parsons Memorial. We are forever grateful for your support.
Reprinted with permission from Dana-Farber Cancer Institute. To learn more, visit www.dana-farber.org.
Pancreatic cancer carries a high mortality rate due in large part to diagnosis occurring late in the disease process, when curative therapies are no longer a viable option. Details on how your generosity has furthered research in the early detection of pancreatic cancer is outlined in the 2019 Progress Update.
Your commitment to Dana-Farber is having an impact on a number of important fronts. The Bob Parsons Fellowship is supporting some of the most promising junior investigators at Dana-Farber as they work to elucidate the underlying biology of pancreatic cancer research, and your philanthropy is bolstering their efforts to improve patient experiences and outcomes.